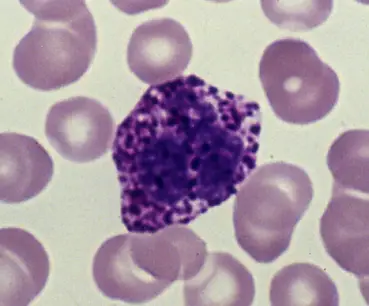
圖片描述

112年:(醫檢)血液(2)
圖中是那種類型的白血球?
ALymphocyte
BBasophil
CNatural killer cell
DEosinophil
詳細解析
本題觀念:
白血球分類與顆粒性白血球的形態學鑑別,特別是基於染色顆粒特徵區分Basophil與其他白血球。
影像分析:
從顯微鏡影像可見一顆大型白血球,其胞質被數十個大而不規則的深紫色(basophilic)顆粒充滿,這些顆粒密集以致遮蔽了核的輪廓。周圍分布著正常大小、淡粉紅色的紅血球。此類染色特徵(深藍紫色顆粒)並非嗜酸性或中性顆粒常見顏色,顆粒幅度顯著大於嗜中性球的細小淡粉或灰藍顆粒,也不同於嗜酸性球的橘紅色顆粒,強烈指向嗜鹼性球(Basophil)的典型表現。
選項分析
-
選項A Lymphocyte
淋巴球核大且幾乎佔滿整個細胞,胞質稀薄、無明顯顆粒。影像中細胞胞質內有大量顆粒,與淋巴球形態不符。 -
選項B Basophil
嗜鹼性球胞質充滿大而深紫色的顆粒,可遮蔽核的輪廓,顆粒內含histamine及heparin。影像正呈現此特徵,符合Basophil典型形態(myhematology.com)([hematology.mlsascp.com](https://hematology.mlsascp.com/morphologies.html?utm_source=opena
...(解析預覽)...

升級 VIP 解鎖圖文解析